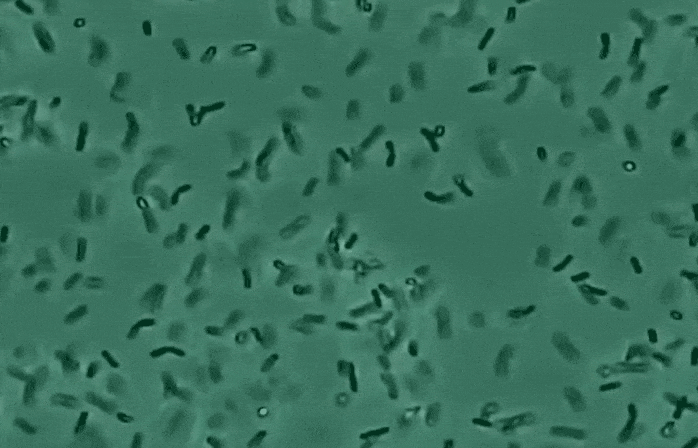
교대역치과 러버댐을 쓰는 곳을 찾아야 하는 이유 관련 이미지 5

오늘도 진료가 끝난 늦은 저녁,
불이 꺼진 진료실과 적막한 원장실에
혼자 앉아 하루를 돌아보며
문득 오늘 있었던 일을 환자분들께도 공유하면
좋을 것 같다는 생각이 들었습니다.
최근 한 달 동안 열심히 내원하셨던 환자분께서
선생님은 왜 꼭 이 고무막 같은 걸 하세요?
라고 물으셨죠.

이 분은 치과 치료 경험이 매우 많으신 분으로
다른 치과에서 진료받을 때는
아주 가끔 썼는데,
여기서는 자주 쓰는 것 같아서
궁금해서요~
라고 말씀하셨습니다.
그 질문을 들을 때면 저는 잠시 멈추고,
조심스레 설명드리게 됩니다.
그 고무막의 이름은 ‘러버댐’입니다.

처음 해보시는 분들께는 낯설고
불편하게 느껴지실 수도 있습니다.
꽉 조이는 느낌이 들고,
구호흡을 하시는 분들께는 호흡이 힘들어
더 힘든 기구가 될 수도 있어요ㅠㅠ
하지만 저는 이 러버댐을,
제가 지키고자 하는 약속의 상징이라 생각합니다.
오늘은 제가 반드시 러버댐을 사용하는 이유
3가지에 대해 말씀드려 볼게요.
첫 번째 : 접착력을 위해서
교대역치과
레진 치료는 수분에 매우 약해서,
아주 조금의 침이나 습기만 닿아도
치료 결과에 악영향을 줄 수 있습니다.
치료가 단단하고 오래가기 위해서는
철저히 마른 환경이 필요합니다.
러버댐은 그 환경을 만들어주는
가장 확실한 도구입니다.


두 번째 : 감염 예방을 위해서
교대역치과
우리 입속 침에는 수많은 세균이 존재합니다.
그 세균이 치료 부위에 닿지 않도록,
러버댐은 깨끗한 치료 환경을 유지해 줍니다.
눈에 보이진 않지만,
환자분의 몸 안에 들어가는 모든 재료가
최대한 청결한 상태에서 자리 잡을 수 있도록
도와주는 역할을 합니다.
세 번째 : 환자분의 안전을 지키기 위해서
교대역치과
러버댐은 레진 치료시 뿐만 아니라,
신경치료 시에도 사용하는데요.

신경치료에 사용하는 약물 중에는
락스처럼 매우 강한 성분이 포함된 것도 있습니다.
그 약물이 입속에 닿으면 안 되기 때문에,
저는 언제나 조심 또 조심하며 치료에 임합니다.
이때 러버댐은 혹시 모를 사고를 막아주는
가장 확실한 보호막이 되어줍니다.
정말 매 환자분을
제 가족을 치료하는 마음으로 진료를 하니
눈에 보이지 않는 부분까지도
세심하게 신경 쓰게 되는데요.
그러다 보니 거의 모든 진료에
러버댐을 사용할 수밖에 없더라고요.
진료 시작 전, 저는 매일 조용히 다짐합니다.
'환자 한 분 한 분께
해드릴 수 있는 최선을 다하자!'라고요.
오늘도 그 작은 고무막을 씌우며,
저는 치료 이상의 마음을 전하고 있습니다.
오늘은 이렇게 약간 간질거리면서도
저의 진심을 담은 글을 한 번 써보았습니다^^;
항상 환자분들을 위한 마음은 정말 가득인데
이걸 표현 안 하면 전달되지 않으니
가끔씩 이렇게 블로그에 써야겠다는 생각을 했습니다.
앞으로도 종종 저의 마음을 담은 글을 써볼 테니
간지러우시겠지만...^^;;
읽어봐주시면 감사하겠습니다🙏🏻